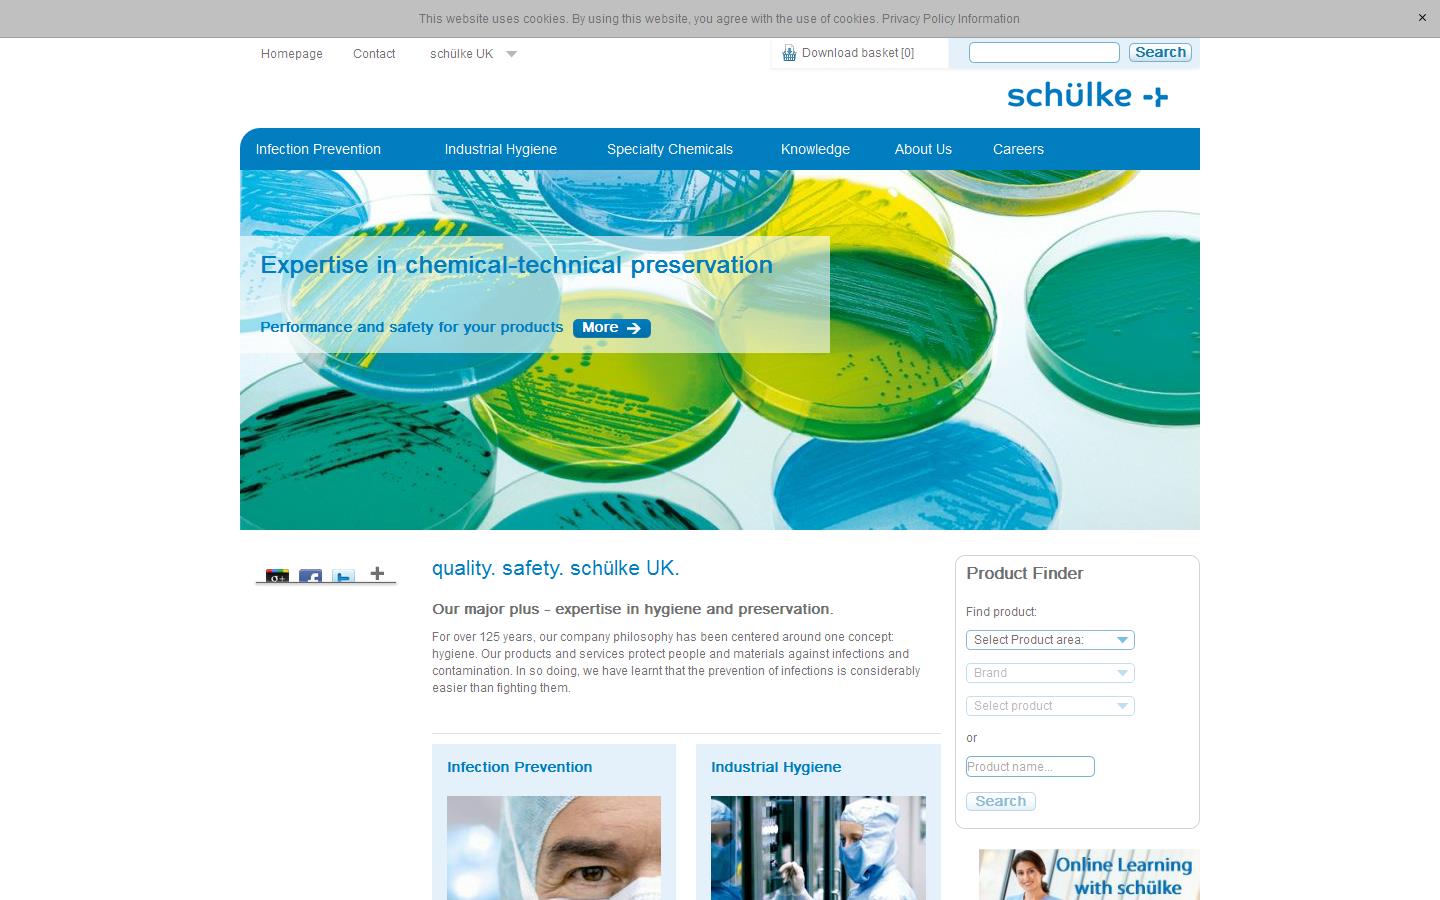
Schuelke & Mayr UK Ltd Website

Company details for:
Schuelke & Mayr UK Ltd
(0)
Cygnet House,
1 Jenkin Road,
Sheffield,
South Yorkshire,
S9 1AT,
United Kingdom
Quick Links:
About us
Instrumentation